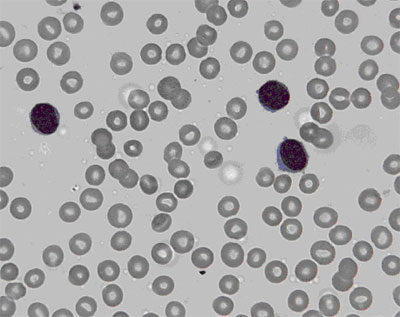

Labor Quiz 7
Ein 61-jähriger, übergewichtiger Typ 2 Diabetiker, der nie in den Tropen weilte, erscheint zur Routinekontrolle in Ihrer Sprechstunde. Neben einem immer noch schlechten HbA1c von 8,5% fällt Ihnen eine Leukozytose von 9,6 G/L mit 80% Lymphozyten im Differentialblutbild auf.
Sie reden während der Konsultation nicht nur über lifestyle Verhalten, sondern untersuchen den Patienten gründlich und stellen als einzigen pathologischen Befund eine massive Splenomegalie fest.
Das Blutbild sieht folgendermassen aus:
- Hb 135 g/L (140-180); Hk 40%(42-52)
- MCV 87 fl (80-102); MCH 29.3 fg (27-33); MCHC 33.6% (30-35)
- Thrombozyten 132 G/L (130-400)
- Leukozyten 9.6G/L (3-9); Stab 2% (3-18); Seg. 14% (35-67); Eos. 2% (-5); Baso 0% (-1); Mono 2% (1-12); Lymph 80% (15-46)
|
Blutausstrich | |
Frage 1
An welche Krankheit denken Sie hier in erster Linie?
|
Frage 2
Welche Untersuchung könnte hier am besten die Diagnose sichern?
|
Frage 3
Welche Schlussfolgerung ziehen Sie aus dem Ergebnis der gemachten Untersuchung?
|
Frage 4
Welche Aussage bezüglich der Therapie dieses Leidens ist richtig?
|
Mediscope
25.08.2004 - dde